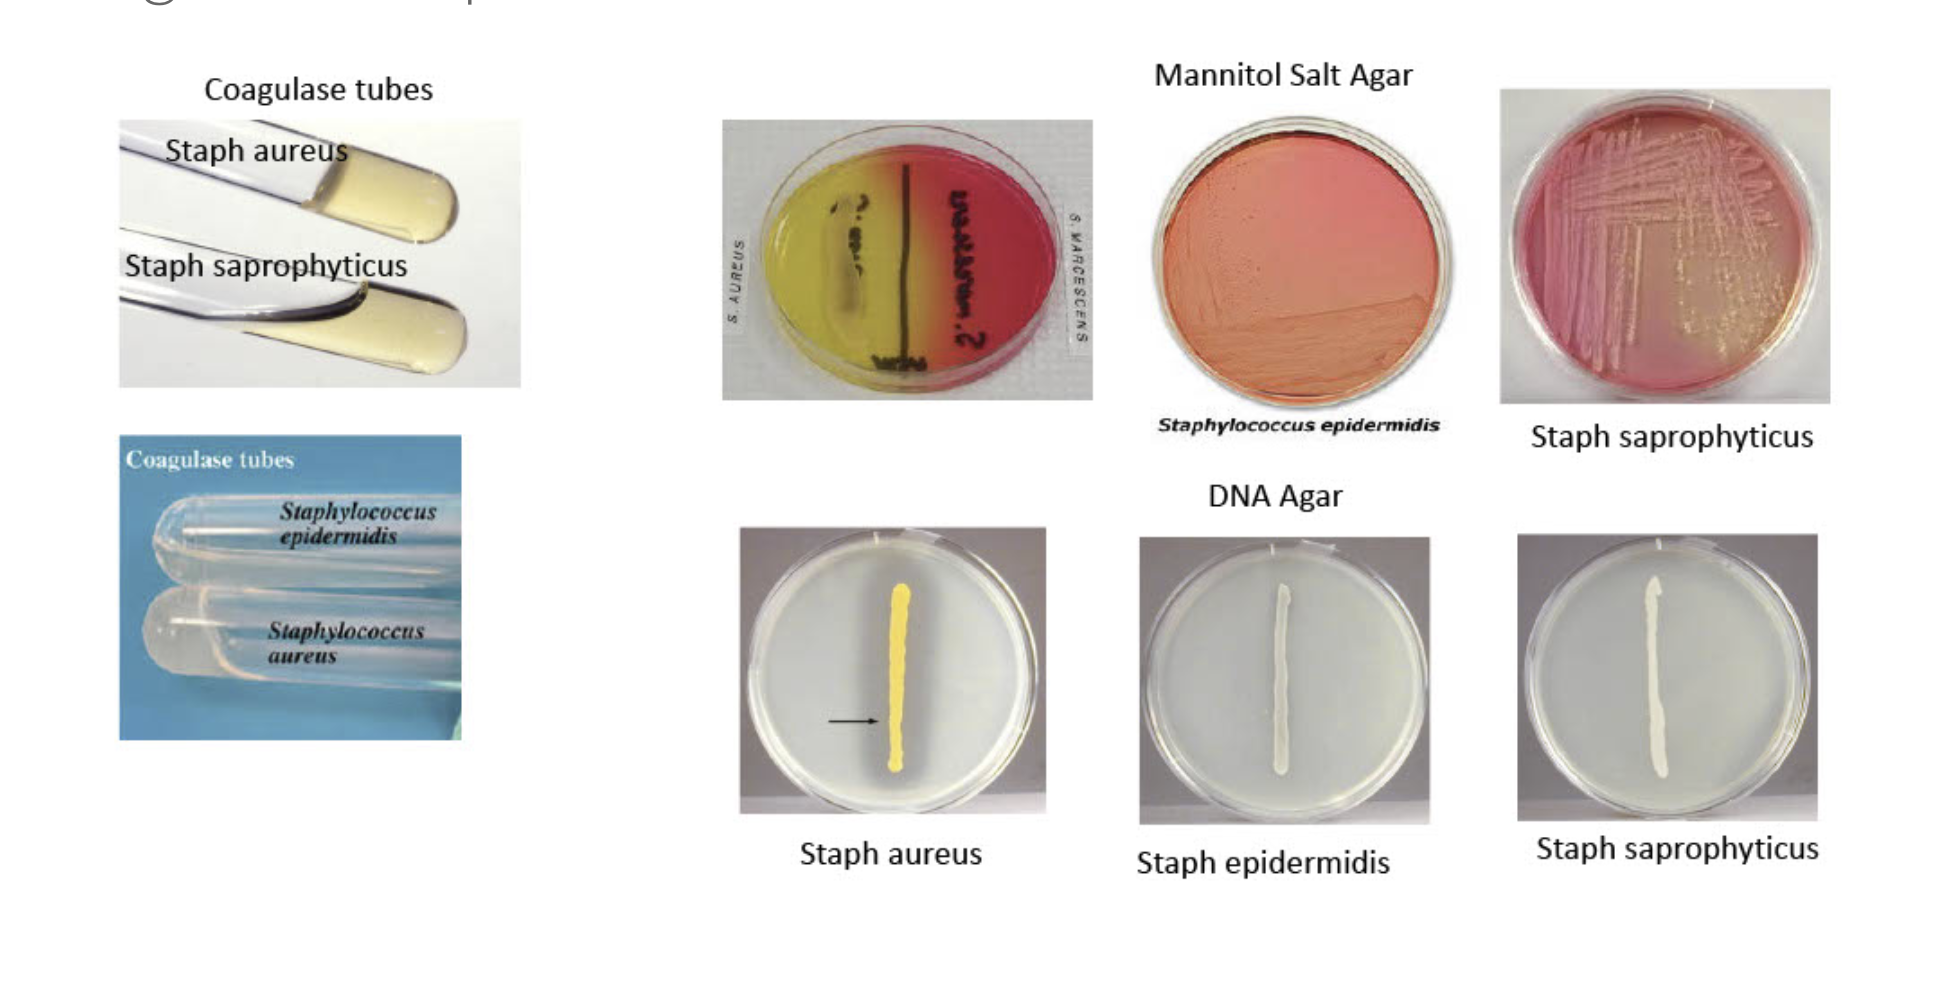
I Don T Understand How I Am Suppose To Fill Out Th Chegg Com

[最新] msa plate staphylococcus epidermidis 214893-Msa plate staphylococcus epidermidis
Mannitol Salt Agar (Figure 1) Table 1 Differential characteristics of the genus Staphylococcus Organism S aureus S epidermidis S saprophyticus Coagulase positive negative negative Novobiocin Susceptibility (>17 mm) sensitive sensitive resistant Mannitol Fermentation positiveMannitol Salt Agar contains beef extract and proteose peptone, which makes it very nutritious as they provide essential growth factors and trace nutrients Many other bacteria except Staphylococci are inhibited by 75% sodium chloride Mannitol is the fermentable carbohydrate source Staphylococcus aureus grows on this medium andMSA Plate @ 24 hrs Mannitol negative Staphylococcus epidermidis Plate report 4 Man neg 4 Man neg

Mannitol Salt Agar Microbiology Food And Drug Reference
Msa plate staphylococcus epidermidis
Msa plate staphylococcus epidermidis-Staphylococcus epidermidis is a commensal that lives on human skin It is nonpathogenic in most circumstances Chronically ill patients with indwelling catheters are prone to urinary tract infections caused by Staphylococcus epidermidis This organism can grow as a biofilm, enhancing its ability to glide over surfaces (such as catheters)Video 3 Staphylococcus epidermidis on Blood Agar with a NB Disc Video 4 Staphylococcus saprophyticus on Blood Agar with a NB Disc Video 5 How to Interpret Mannitol Salt Agar Streak your unknown for isolation on a plate of Mannitol Salt agar (MSA) as shown in Fig 3



Got Science Notanotherscienceblog Staphylococcus Aureus On
Growth on the MSA plate without yellow color, gamma hemolysis of the blood on the SBA plate (blood not lysed;Jun 28, · Mannitol Salt Agar (MSA) This is a medium that is both selective and differential The high salt concentration (75%) is the selective ingredient Staphylococcus species, which commonly inhabit human skin, can grow on this high salt concentration (left plate in picture below)Apr 06, 16 · Staphylococcus is a genus of Gram , nonsporeforming cocci belonging to the family Micrococcaceae that are often found as normal human microbiota of the skin and nasal cavityThere are five organisms to consider as potential human pathogens in this genus S aureus, S epidermidis, S saprophiticus, S haemolyticus, and S hominis but the first three are the most
Dec 01, 12 · Suppose that you streak a MSA plate with Staphylococcus epidermidis and incubate the plate at 37 C for 2436 hours Describe the expected appearance of the agar after incubation agar should remain pink Suppose that you streak a SM110 plate with Staphylococcus aureus and incubate the plate at 37 C for 2436 hoursMSA contains a high concentration of salt (NaCl), and therefore, selects for the growth of microbes that can tolerate high salt concentrations Staphylococcus species are halotolerant, whereas Streptococcus species and many other organisms are inhibited by high concentrations of NaCl MSA also differentiates on the basis of mannitol fermentationFeb 25, · Mannitol salt agar or MSA is a commonly used selective and differential growth medium in microbiology It is also a differential medium for mannitolfermenting staphylococci, containing carbohydrate mannitol and the indicator phenol red, a pH indicator for detecting acid produced by mannitolfermenting staphylococci Click to see full answer
Jun 26, 19 · MANNITOL SALT AGAR PLATE (MSA) Selective for grampositive bacterium (eg Staphylococcus) Mannitol fermentation by pathogenic staphylococci, such as S aureus and S simulans is indicated by the agar media changing fromUsing a Sharpie, divide plate into two sections and label each with the appropriate organism, your name, and the date 2 Using aseptic technique, streak a small amount of Staphylococcus aureus and Staphylococcus epidermidis on opposite sides of an MSA plate 3 Describe the appearance of the medium before inoculation 4 Incubate the plate forNo zone around the colony, purple/white colonies present) Staphylococcus epidermidis Features



Asmscience Mannitol Salt Agar Plates Protocols



Microbiology Notes And Updates Growth Of Staphylococcus Aureus Yellow And Staphylococcus Epidermidis Red On Mannitol Salt Agar Plate Image By Matthew Donadu Facebook
MSA Plate @48 hrs MSA Plate Novobiocin Pie Plate Furazolidine S aureus S epidermidis Micrococcus and StaphylococcusSE= Staphylococcus epidermidis Gram positive EA= Enterobacter aerogenes G EC= Escherichia coli Gram negative SA= Staphylococcus aureus G, staph EF= Enterococcus faecalis G SP= Streptococcus pyogenes G SV= Streptococcus viridans GFeb 04, 21 · Limitations of Mannitol Salt Agar (MSA) Several Staphylococcus species other than aureus are mannitol positive and produce yellow colonies surrounded by yellow zones on this medium (eg S capitis, S xylosus, S cohnii, S sciuri, S simulans, and other species)Therefore, further biochemical tests are necessary for the identification of S aureus or other species



Mannitol Salt Agar Msa Composition Uses And Colony Characteristics Learn Microbiology Online



Staphylococcus Aureus Staphylococcus Epidermidis Streptococcus Pneumoniae And Streptococcus Pyogenes On Mannitol Salt Agar Plates Containing Ppt Download
Jan 04, · Mannitol salt agar is a commonly used growth medium in microbiology It encourages the growth of a group of certain bacteria while inhibiting the growth of others Will E coli grow on mannitol salt agar?(Growth Or No Growth) Describe The ColorJun 27, 14 · Friedrich Julius Rosenbach found the differences between Staphylococcus Epidermidis and Staphylococcus Aureus in 14, it is a hard microorganism consisting of nonmotile Gram cocci, arranged in grapelike clusters S epidermidis has the ability to form biofilms on plastic devices, causing a major virulent factor The biofilm that grows on



Figure A Presumptive Of S Aureus On Mannitol Salt Agar Download Scientific Diagram



A Staphylococcus Aureus And Staphylococcus Epidermidis Grown On Download Scientific Diagram
MSA SE ΕΑ se EC Out of all the given species, which one should have survived on this MSA Plate?(A) Staphylococcus aureus, (B) Staphylococcus epidermidis, and (C) Escherichia coli streaked on a mannitol salt agar plateS epidermidis is negative for growth on MAC, is positive for growth on PEA and MSA Purpose To test your unknown bacteria on several differential and selective media You will need to compare this growth to growth on a control TSA or NA plate



A Staphylococcus Aureus And B Staphylococcus Epidermidis On Download Scientific Diagram



Pdf Mannitol Salt Agar Semantic Scholar
Epidermidis Mannitol Salt Agar Plate Results Staphylococcus Saprophyticus Apply Tienen Staphylococcus Epidermidis EMSA) Mannitol Salt Agar Foph Aureus Staphylococcus Aureus Streptococcus Mitis (there's A Typo On The Plate) Sllove Dants MSA Plate Organism Was There Growth For This Microbe On The Plate?Aims To investigate the use of mannitol salt agar (MSA) supplemented with acriflavine for selective growth and quantification of Staphylococcus aureus from flushed dairy manure wastewater (FDMW) Methods and Results Minimal inhibitory concentrations of acriflavine in MSA were determined by comparing the growth of S aureus subsp aureus (ATCC ) and Staphylococcus epidermidisOne mannitol salt agar (MSA) plate 2 One blood agar plate 3 Overnight broth cultures of Staphylococcus aureus, Staphylococcus epidermidis, and Enterococcus faecalis (on plate) 4 Sterile swabs and sterile toothpicks 5 Rabbit plasma 6 10 and 01 ml pipets 7 3% Hydrogen peroxide solution Procedure (work in pairs) 1



Microbiology Differential Lab Flashcards Quizlet



L13 Medical Microbiology Laboratory Staphylococcus Spp
Dec 28, 12 · The tests ran on the Grampositive unknown (Staphylococcus epidermidis) were as followed Mannitol Salt Agar, Methyl Red, Catalase, and Urea The observations after the incubation on the Mannitol Salt Agar concluded that the bacterium ferments mannitol



Bacterial Colonies Streak Plate Free Images Photographs Page 2



Microbiology And Beauty What Has Been Made



Welcome To Microbugz Mannitol Salt Agar



Mannitol Salt Agar Msa Test Scientist Cindy



Mannitol Salt Agar Microbiology Food And Drug Reference



Mannitol Salt Agar Msa With Oxacillin For The Detection Of Methiciliin Resistant Staphylococcus Aureus



Pin On Science Stuff



Staphylococci Prac Microbiology


Mannitol Salt Agar Msa Plate



Mannitol Salt Agar Msa Test Superfarmer S Weblog



Prevalence Of Methicillin Resistant Staphylococcus Aureus In Shrines



Got Science Notanotherscienceblog Staphylococcus Aureus On


Mannitol Salt Agar Msa Culture Media Key Scientific Products



What Is Mannitol Salt Agar Biology Wise



Pin On Microbiology



Pin On Tasha Sturm Everything Microbiology



Staphylococcus Aureus Staphylococcus Saprophyticus On Mannitol Stock Photo Edit Now



Solved Skin Cultur Mannitol Salt Agar Plates Inoculated W Chegg Com


Microbiology Lab Molb 2210



Yellow Colonies Of S Aureus On Mannitol Salt Agar Download Scientific Diagram



Staphylococcus Epidermidis Msa Page 1 Line 17qq Com



Mannitol Salt Agar Microbiology Food And Drug Reference



Microbiology Notes And Updates Mannitol Salt Agar Plate Staphylococcus Aureus Left And Staphylococcus Epidermidis Right Source Imgrum Clinical Microbiology Facebook



Staphylococcus Epidermidis Msa Test Page 1 Line 17qq Com


Mannitol Salt Agar


Biol 230 Lab Manual Staphylococcus Epidermidis On Mannitol Salt Agar



Mannitol Salt Bacterial Growth Medium Msa Page 2


Mannitol Salt Agar Msa Introduction Composition Preparation Uses And



Mannitol Salt Agar Msa Test Scientist Cindy



Mannitol Salt Agar Msa Results Theory Youtube



Mannitol Salt Agar Images Stock Photos Vectors Shutterstock



Mannitol Salt Agar Msa Composition Uses And Colony Characteristics Learn Microbiology Online



Solved Stoph Epidermidis Mannitol Salt Agar Plate Resul Chegg Com



Typical Golden Yellow Colonies Of Staphylococcus Aureus On Mannitol Download Scientific Diagram



Selective Growth Of Staphylococcus Aureus From Flushed Dairy Manure Wastewater Using Acriflavine Supplemented Mannitol Salt Agar Davis 06 Letters In Applied Microbiology Wiley Online Library



Lab 5 Integumentary System Bacteriology And Identification Ppt Download



Staphylococcus Aureus Grow On Mannitol Salt Stock Photo Edit Now



On Msa Mannitol Salt Agar Staphylococcus Aureus Colonies Will



Growth On Mannitol Salt Agar Media Showing Presence Of Yellow Halo Download Scientific Diagram



Exercise 51 Staphylococci Flashcards Quizlet



Mannitol Salt Agar Microbiology Images Photographs From Science Prof Online



Staphylococcus Aureus Characteristics Biochemical Tests And Others Lab Tests Guide



Lab 12 Staphylococcus And Streptococcus Biology Libretexts



Staphylococcus Epidermidis On Agar Plate With Mannitol Salt Agar Chapman Agar Growth Of S Epidermidis In Petri Dish On Chapman Agar Medium Appearance And Morphology Of Staphylococcus Epidermidis And S Aureus Colonies On Mannitol



Mannitol Salt Agar Msa Composition Uses And Colony Characteristics Learn Microbiology Online



Mannitol Salt Agar Microbiology Images Photographs From Science Prof Online



Mannitol Salt Agar For The Isolation Of Staphylococcus Aureus


Biol 230 Lab Manual Staphylococcus Saprophyticus On Mannitol Salt Agar



Solved Mannitol Salt Agar Msa Looking At The Selectiv Chegg Com


Untitled Document


Staphylococcus Epidermidis Under Microscope Microscopy Of Gram Positive Cocci Morphology And Microscopic Appearance Of Staphylococcus Epidermidis S Epidermidis Gram Stain And Colony Morphology On Agar Clinical Significance


Staphylococcus Mannitol Salt Agar Plate Medical Laboratories



Staphylococcus



Mannitol Salt Bacterial Growth Medium Msa Page 2


Mannitol Salt Agar Chapman Medium Staphylococcus Aureus And Staphylococcus Epidermidis Colonies On Mannitol Salt Agar Plate



Mannitol Salt Agar Wikipedia



Yellow And Pink Fermentation On Mannitol Salt Agar S Aureus And S Download Scientific Diagram



Mannitol Salt Agar Msa Test Scientist Cindy



Staphylococcus Aureus On Msa Plate Page 1 Line 17qq Com



Staphylococcus Epidermidis An Overview Microbe Notes



Pink Colonies Of Staphylococcus Epidermidis Isolate Grow On Mannitol Download Scientific Diagram



White Raised Colonies Of S Epidermidis On Mannitol Salt Agar Download Scientific Diagram



Article Fulle Text

I Don T Understand How I Am Suppose To Fill Out Th Chegg Com



Mannitol Salt Agar Msa Images Stock Photos Vectors Shutterstock



16 2 Bacterial Infections Of The Skin And Eyes Allied Health Microbiology



Staphylococcus Epidermidis On Msa Plate Page 1 Line 17qq Com



Selective And Differential Media Ppt Video Online Download



Thermo Scientific Mannitol Salt Agar Products Fisher Scientific


Experiment 8c Lab08 Virtual Edge Molb 21 College Of Agriculture And Natural Sciences



Solved Mannitol Salt 1 What Is This Media Selective And Chegg Com


Staphylococcus Aureus And Staphylococcus Epidermidis On Mannitol Salt Agar Mannitol Salt Agar Composition Positive And Negative Result On Mannitol Salt Agar



Mannitol Salt Agar Msa Composition Uses And Colony Characteristics Learn Microbiology Online



Staphylococcus Aureus On Combined Mannitol Salt Agar And Vogel And Johnson Agar Microbiology Pictures Microbe Notes



Mannitol Salt Agar Plate Test Composition Preparation Uses Laboratoryinfo Com



Mannitol Salt Agar Plate With Oxacillin Showing Methicillin Resistant Download Scientific Diagram


Biol 230 Lab Manual Staphylococcus Aureus On Mannitol Salt Agar



Staphylococci Flashcards Quizlet



Staphylococcus Aureus And Staphylococcus Epidermidis On Mannitol Salt Agar


Staphylococcus On Mannitol Salt Agar



Staphylococcus Aureus On Mannitol Salt Agar Joe Rubin Flickr


Biomerieux Culture Media Product Mannitol Salt 2 Agar



Growth Of Staphylococcus Aureus On Mannitol Salt Agar Download Scientific Diagram



Solved Staphylococcus Aureus Staphylococcus Epidermidis M Chegg Com



Mannitol Salt Agar Msa



Asmscience Mannitol Salt Agar Plates Protocols


Mannitol Salt Agar



コメント
コメントを投稿